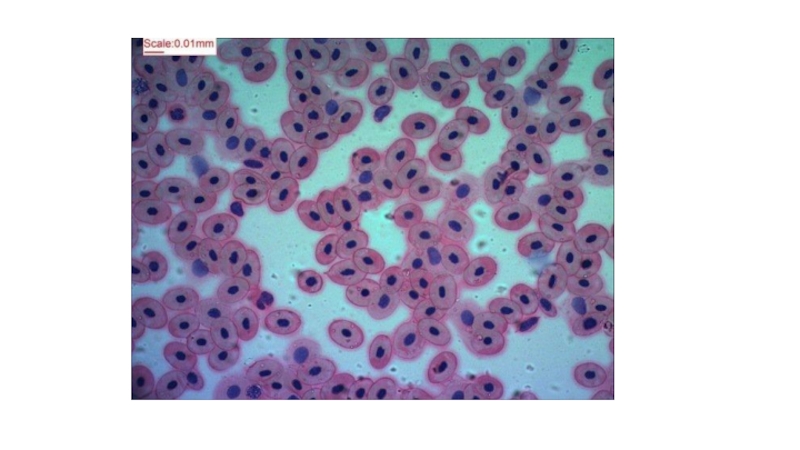

- Главная
- Разное
- Образование
- Спорт
- Естествознание
- Природоведение
- Религиоведение
- Французский язык
- Черчение
- Английский язык
- Астрономия
- Алгебра
- Биология
- География
- Геометрия
- Детские презентации
- Информатика
- История
- Литература
- Математика
- Музыка
- МХК
- Немецкий язык
- ОБЖ
- Обществознание
- Окружающий мир
- Педагогика
- Русский язык
- Технология
- Физика
- Философия
- Химия
- Шаблоны, фоны, картинки для презентаций
- Экология
- Экономика
Презентация, доклад по биологии на тему Кровь (8 класс)
Содержание
- 1. Презентация по биологии на тему Кровь (8 класс)
- 2. Внутренняя среда организмаКровьМежклеточная жидкостьЛимфа
- 3. Межклеточная жидкость
- 4. Лимфа
- 5. Слайд 5
- 6. Слайд 6
- 7. Слайд 7
- 8. Плазма
- 9. Форменные элементы крови
- 10. Слайд 10
- 11. Слайд 11
- 12. Слайд 12
- 13. Слайд 13
- 14. Слайд 14
- 15. Лейкоциты
- 16. Слайд 16
- 17. Слайд 17
- 18. Тромбоциты
- 19. Слайд 19
- 20. Слайд 20
- 21. «Микроскопическое строение крови человека и лягушки»
- 22. Слайд 22
- 23. Слайд 23
- 24. Слайд 24
- 25. Слайд 25
Внутренняя среда организмаКровьМежклеточная жидкостьЛимфа